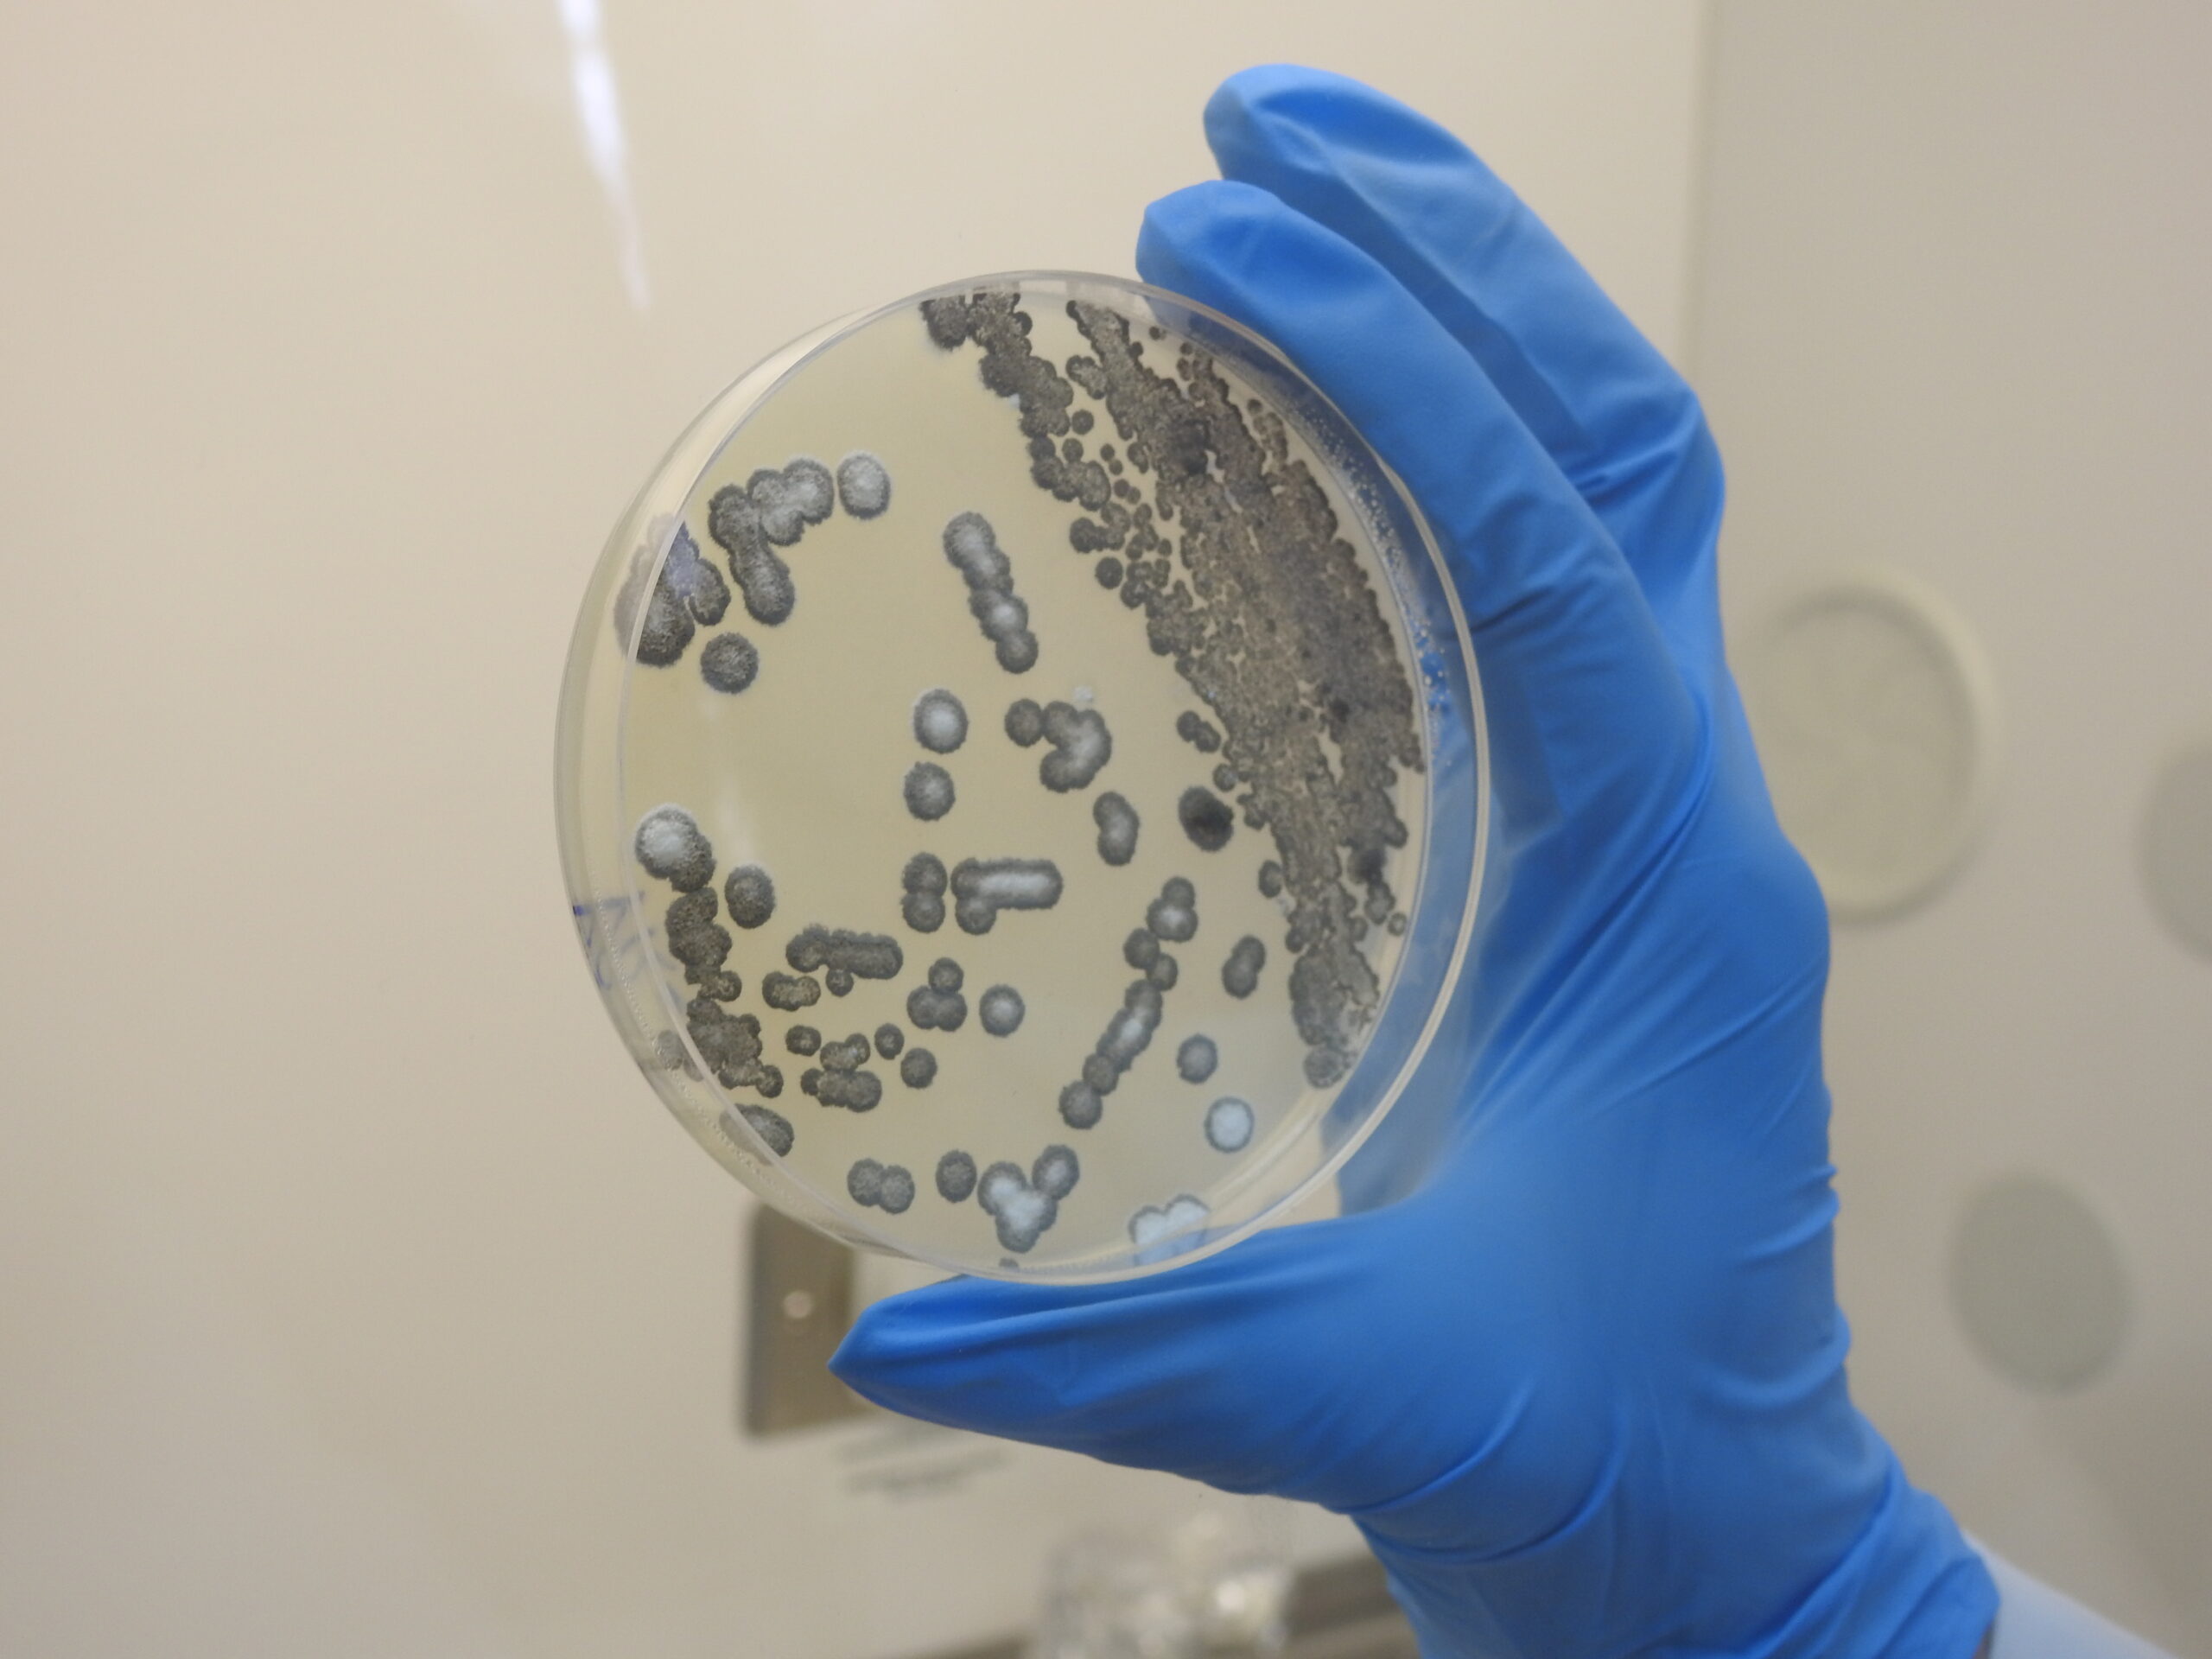

Workshop internacional: Expertos de 11 países debaten sobre toxinas alimentarias
El pasado 3 de marzo de 2026 se realizó el workshop internacional “Toxinas en la Cadena
Agroalimentaria: Impacto en la Salud y Estrategias de Mitigación”, una instancia científica
que reunió a investigadores, profesionales del sector agroalimentario y estudiantes de
postgrado para analizar los desafíos que representan las toxinas para la seguridad
alimentaria global.
La actividad surgió a partir de una colaboración académica entre la Universidad de La
Frontera y la Universidad de O’Higgins, con el objetivo de generar un espacio de
intercambio científico en torno a las micotoxinas y su impacto en la cadena agroalimentaria,
así como las estrategias que actualmente se están desarrollando para su mitigación.
El encuentro convocó a 121 participantes provenientes de universidades, centros de
investigación y organismos gubernamentales de 11 países: Chile, Brasil, México, Colombia,
Paraguay, Argentina, Uruguay, Ecuador, Venezuela, Portugal y República Dominicana. La
diversidad de procedencias permitió enriquecer la discusión desde una perspectiva regional
y global.
Durante la jornada se abordaron diversos temas clave relacionados con la inocuidad
alimentaria, entre ellos el impacto de las micotoxinas en la salud pública, el modelado
predictivo de su comportamiento en escenarios de cambio climático, las estrategias de
mitigación en cultivos clave como el trigo, y los riesgos emergentes asociados a toxinas
bacterianas.
El workshop contó con la participación de especialistas internacionales provenientes de
Chile, Brasil, Reino Unido e Italia, quienes compartieron avances científicos y experiencias
en investigación aplicada al control y monitoreo de toxinas en sistemas agroalimentarios.
Desde la organización destacaron que este tipo de instancias contribuye no solo a la
formación de estudiantes y jóvenes investigadores, sino también al fortalecimiento de redes
de colaboración científica, especialmente en el contexto de América Latina, donde la
producción agrícola y la seguridad alimentaria son temas estratégico, “este workshop
permitió compartir avances, discutir riesgos emergentes y, sobre todo, fortalecer redes de
colaboración entre especialistas que trabajan en inocuidad alimentaria. Esperamos que esta
instancia sea el punto de partida para nuevas colaboraciones científicas y futuras
actividades en esta temática”, señaló Cledir Santos, uno de los organizadores del
encuentro.
El equipo organizador señaló además su interés en seguir promoviendo espacios de diálogo
y cooperación científica en torno a las micotoxinas, con el objetivo de impulsar nuevas
colaboraciones entre investigadores y fortalecer la investigación en esta área a nivel
regional y global.

Comments are closed